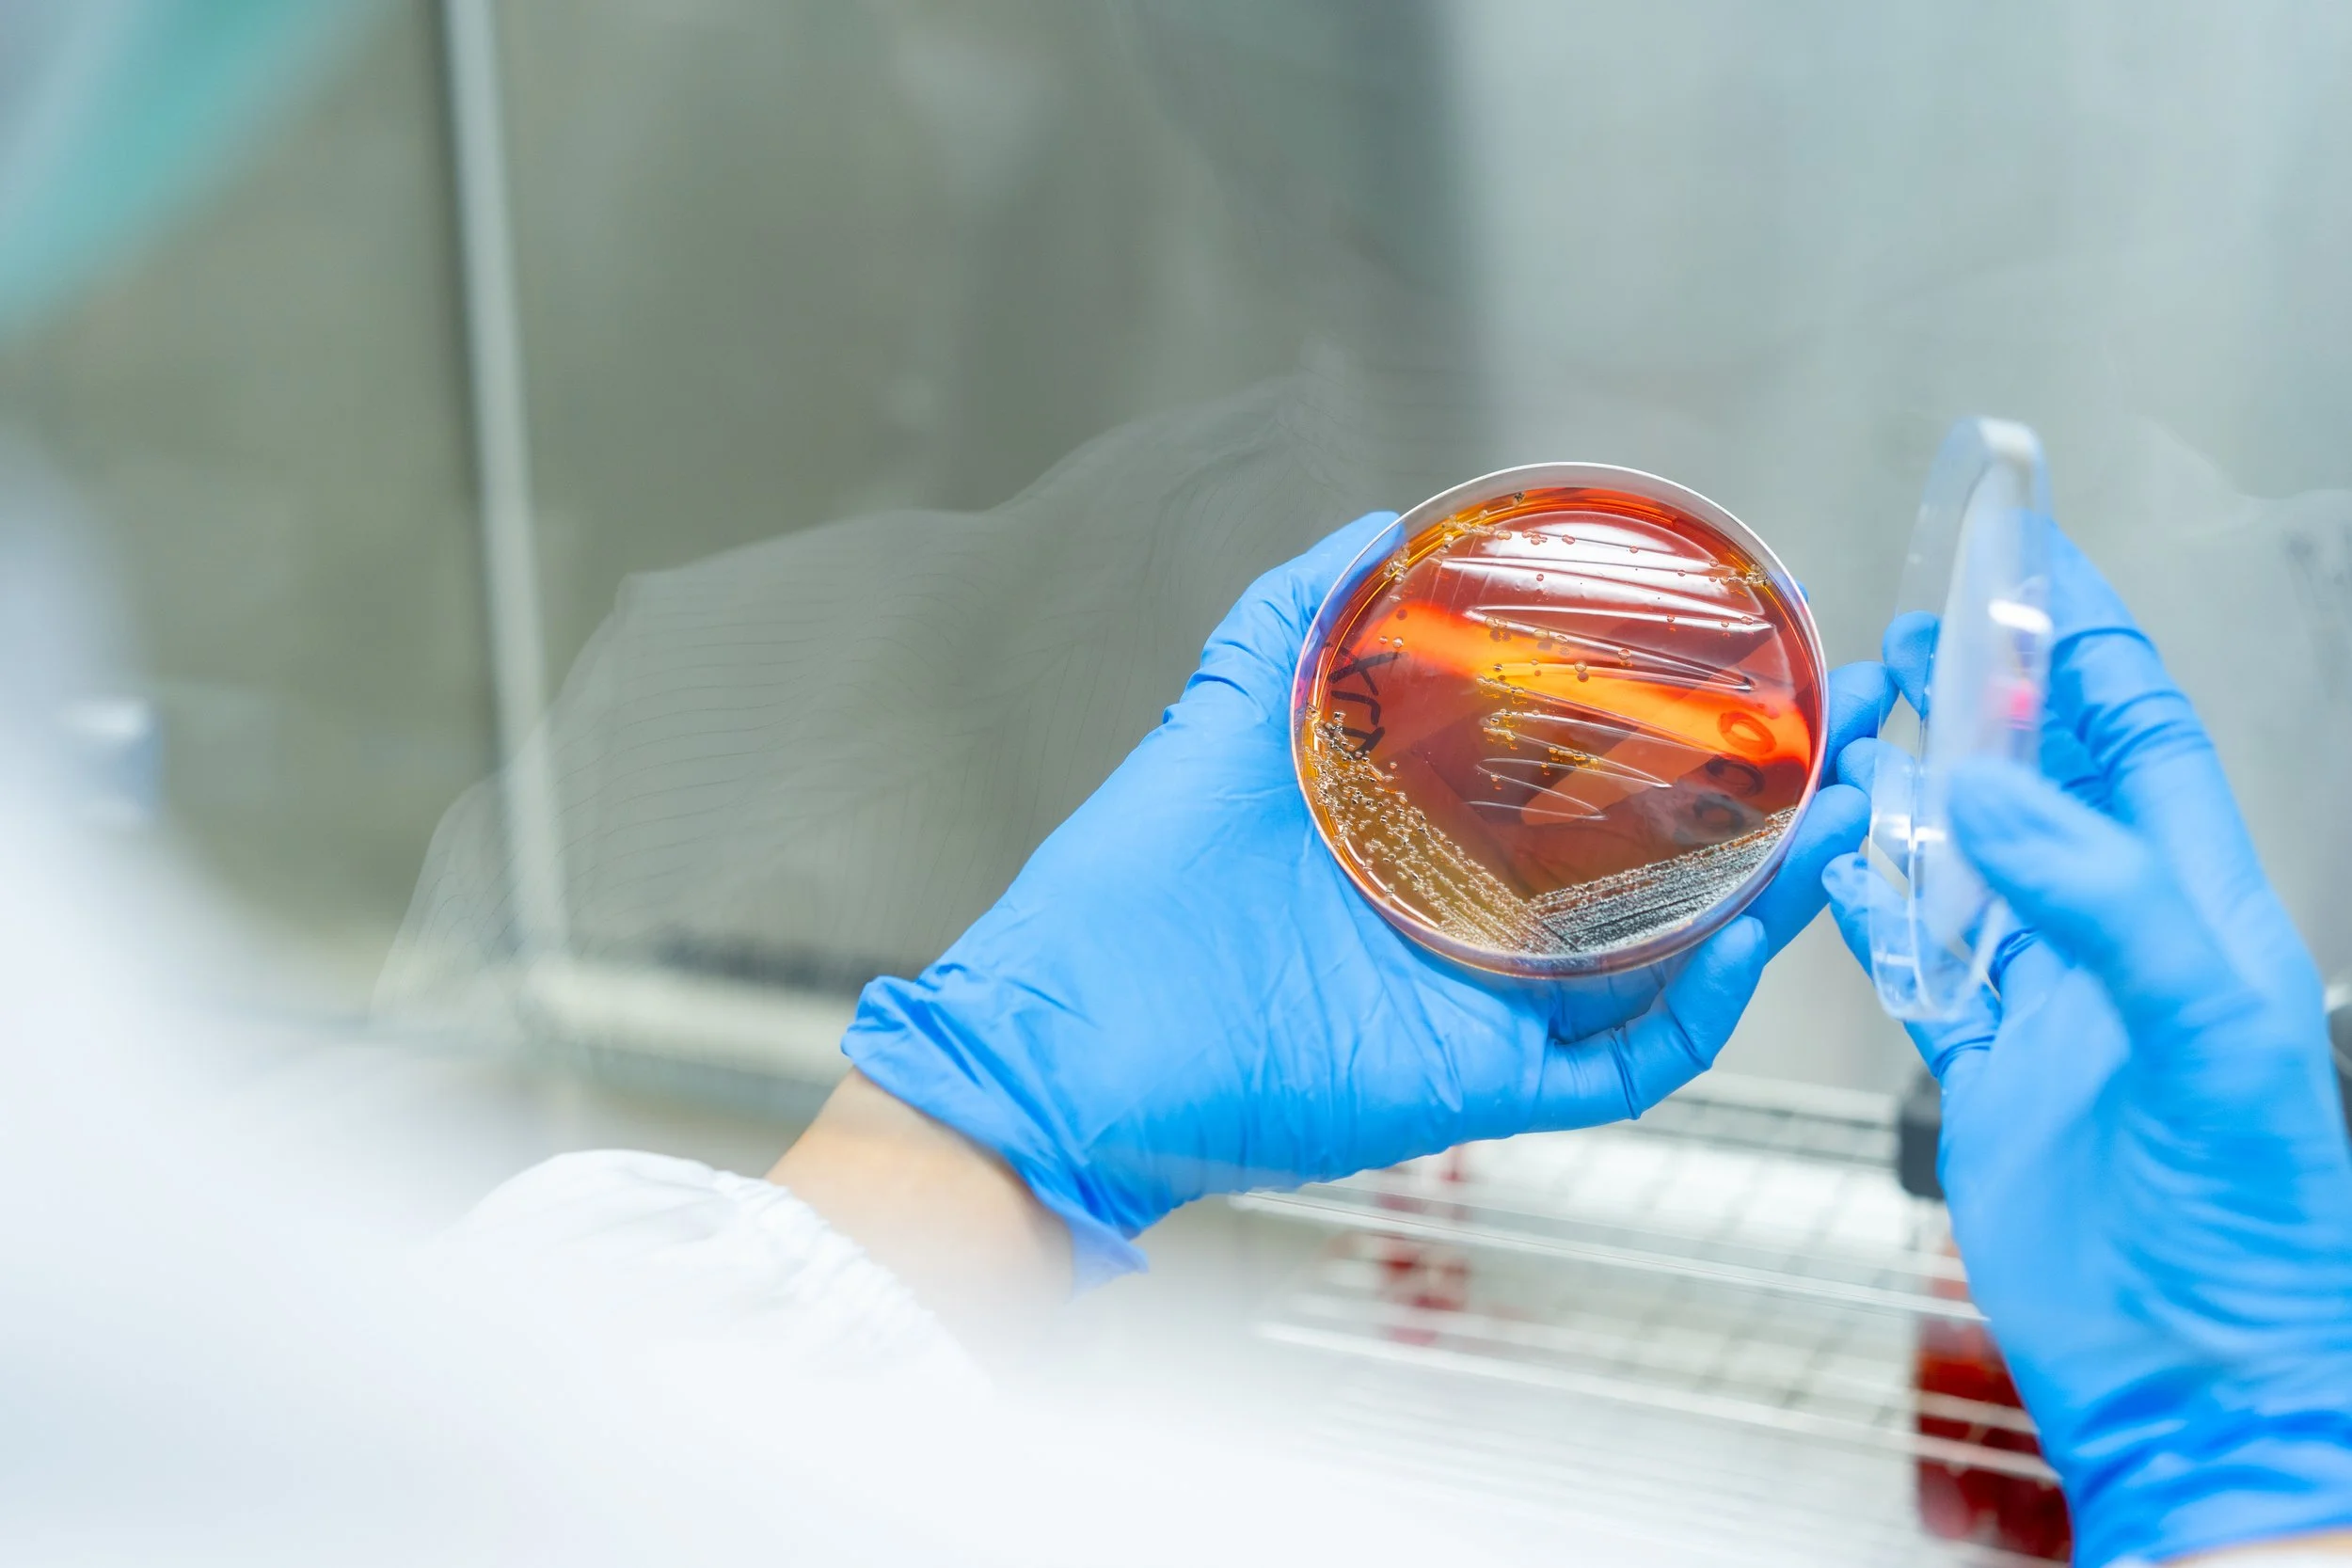
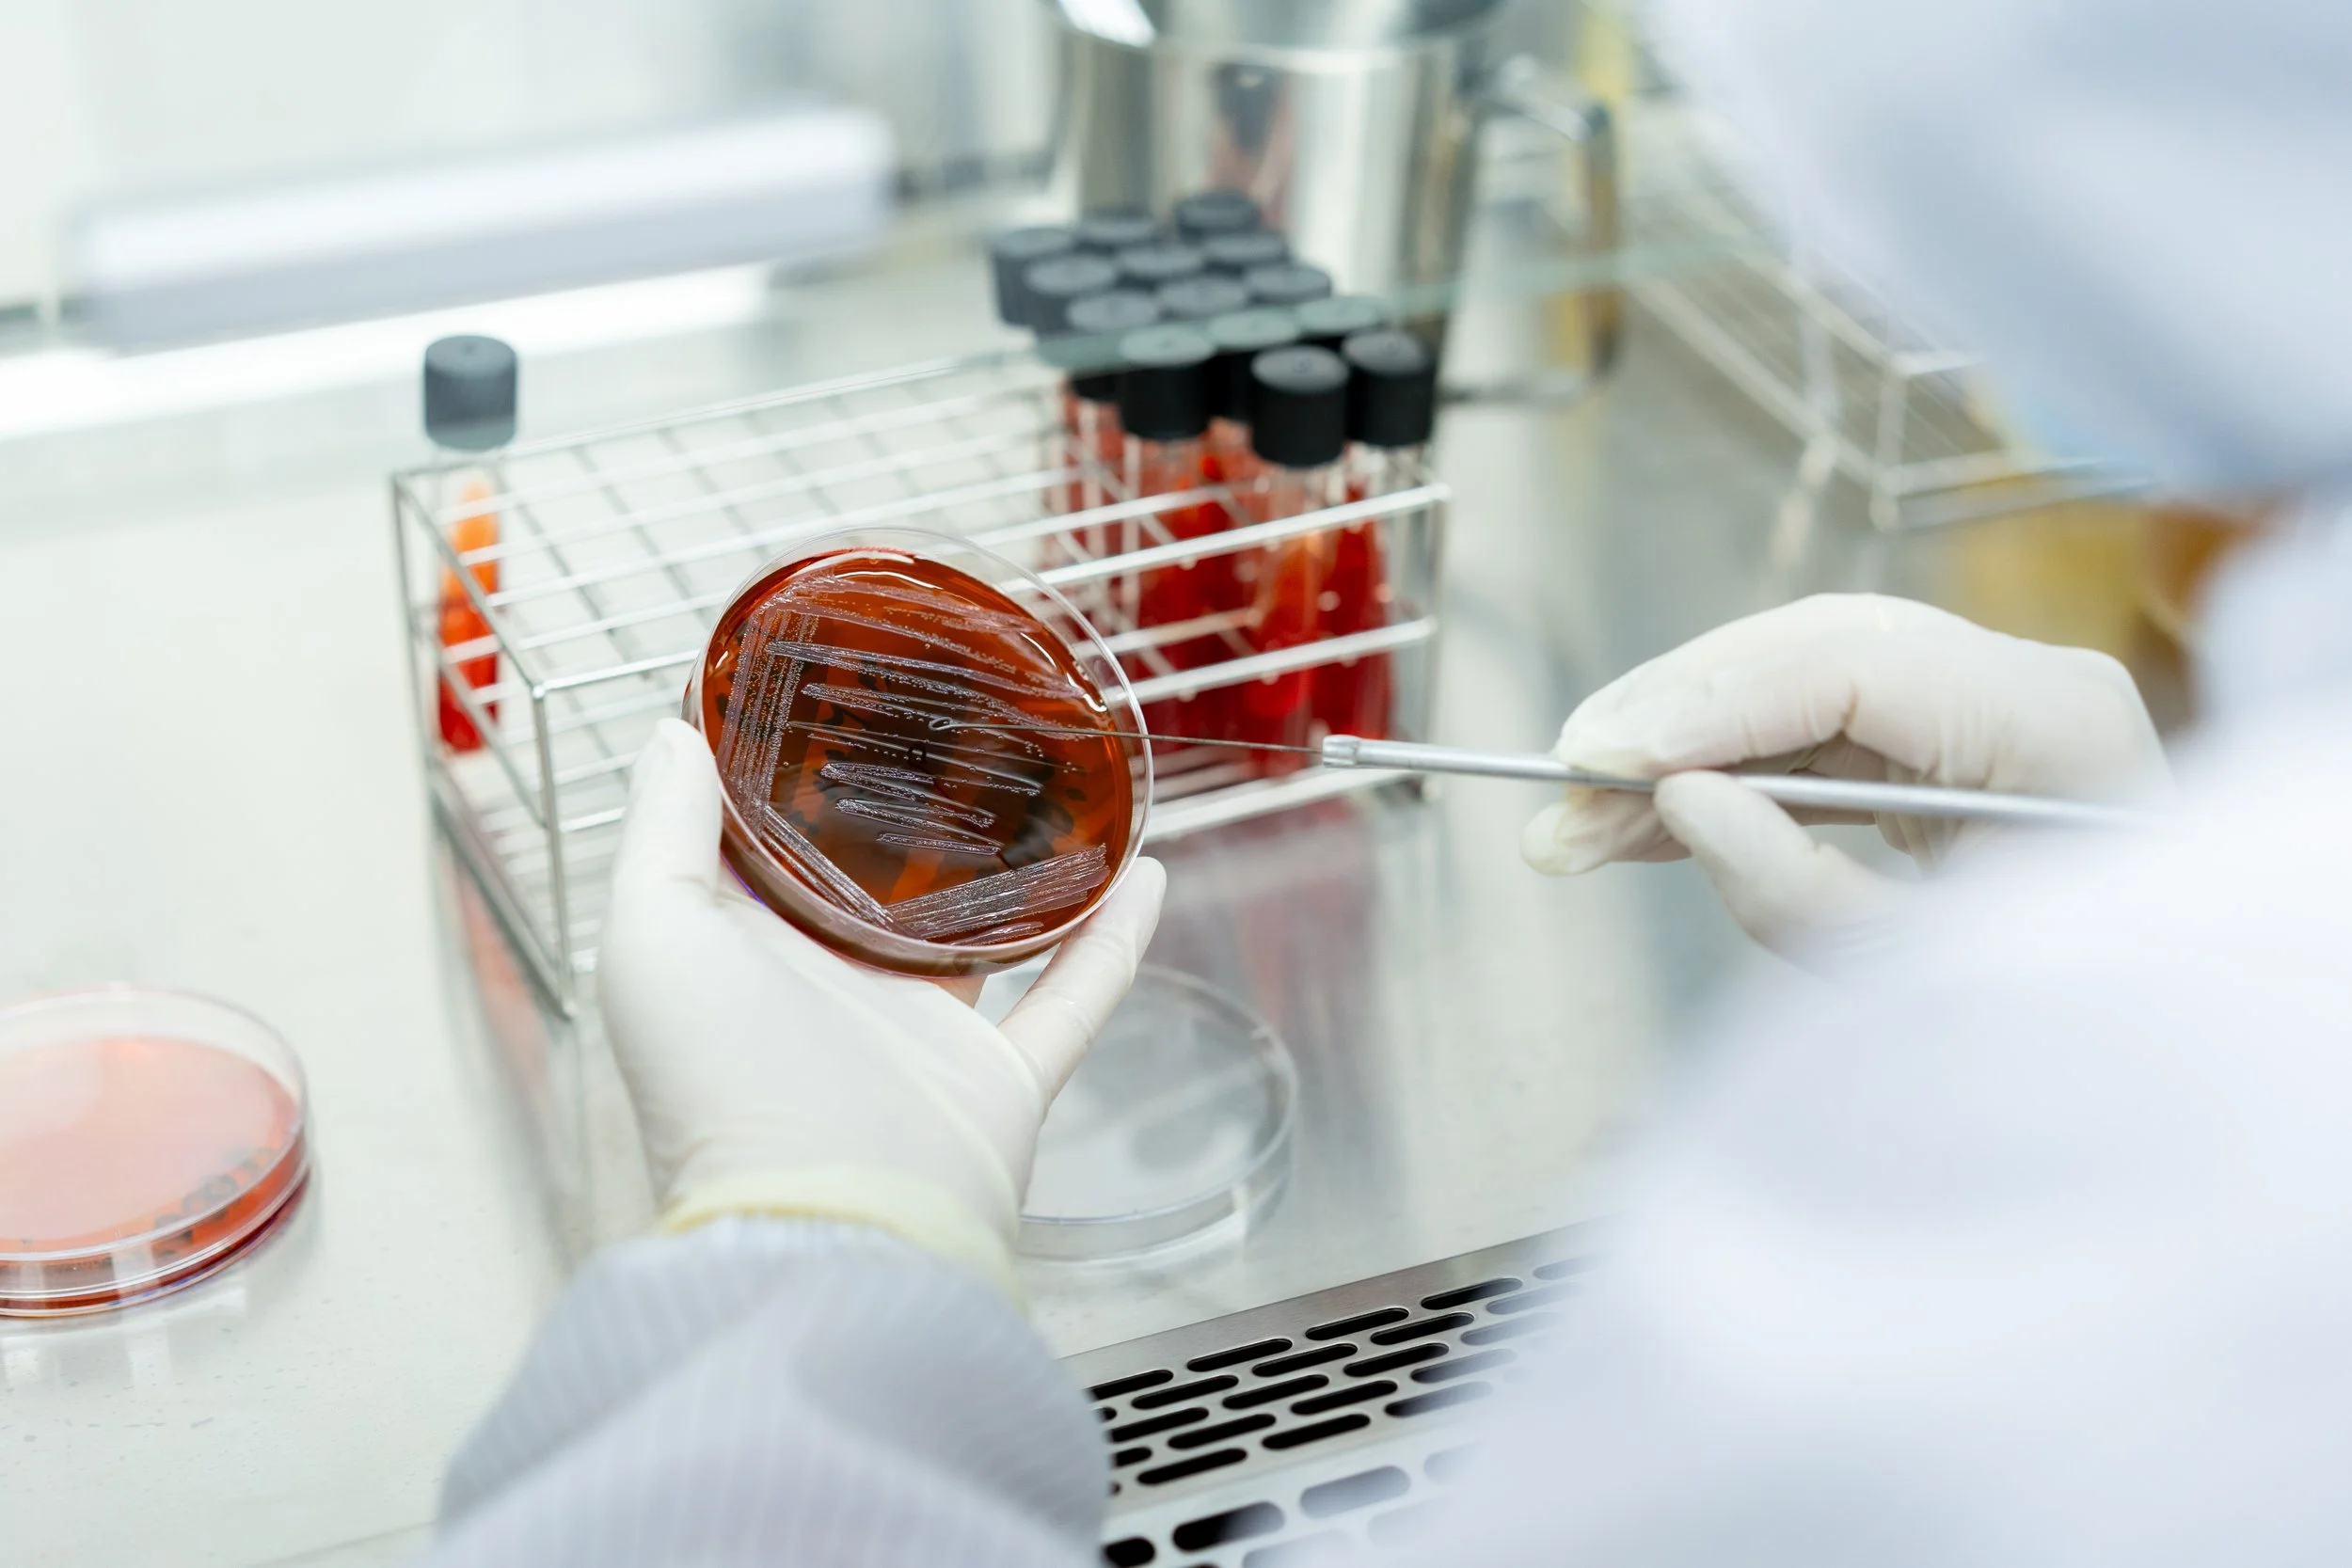

SIAM HERBAL TECH
SCIENCE OF NATURAL
Siam Herbal Tech (SHT) is a wholly owned subsidiary of Pacific Cannovation Company Limited
(PACCAN). PACCAN and SHT bring best in class technology and innovation, proven experience, and quality standard, to consistently produce the highest-grade plant-based therapeutic compounds for our customers. We work with our partners and customers to create high efficacy and safe standards, using the power of natural therapeutics. We are a fully integrated group, from upstream cultivation of herbal plants to midstream extraction, and to downstream final product development.
✳︎
SIAM HERBAL TECH
✳︎
✳︎ SIAM HERBAL TECH ✳︎


ABOUT US

Our Products



Product & Services

-

Knowledge Bank
-

Grow Partners
-

New & Events

Our Partners


Dod Biotech
Pacific Cannovation

Lavender Boys

Cali Dior Frams

CannaBuri
Featured In











CONTACT US
CONTACT US

Contact Us
E-mail : info@siamherbaltech.com
Phone : +66 34-119-775
Address : SIAM HERBAL TECH 288/8 Moo 4, Bang Ya Phraek, Muang-Samutsakorn, Samutsakorn 74000